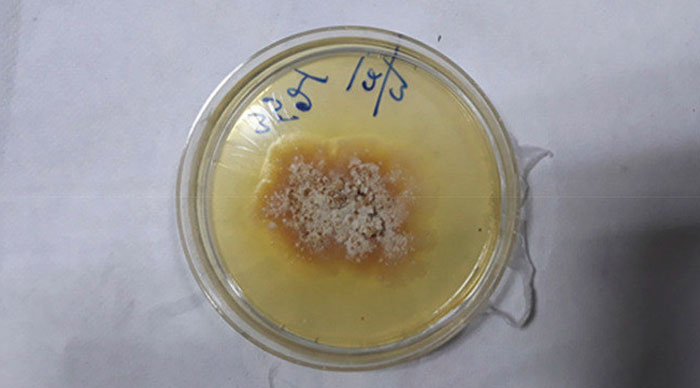

Fungo assassino de plantas infecta homem pela primeira vez na história
O homem estava com um abscesso, que obstruia suas vias aéreas
Por Plox
02/04/2023 16h02 - Atualizado há cerca de 2 anos
Uma história digna de ficção científica se tornou realidade na Índia. Um homem de 61 anos foi infectado por um fungo assassino de plantas. Essa é a primeira vez na história que um ser humano foi infectado por um fungo vegetal.
O caso foi registrado em documentos no periódico científico Medical Mycology Case Reports. Esse caso serve como alerta para os riscos de infecção humana por fungos vegetais. O paciente, um micologista de plantas, foi diagnosticado com Chondrostereum purpureum, causador da doença das folhas prateadas em plantas.
Conforme as informações da imprensa indiana, o homem chegou ao hospital com sintomas semelhantes aos da gripe, como rouquidão, tosse, faringite recorrente, fadiga, dificuldade de deglutição e anorexia.
O paciente foi submetido a uma tomografia e nela que pode ser constado uma infecção na traqueia direita, com pus. Após coleta do material, foi constato se tratar de um fungo que ataca plantas.
Os médicos do Consultant Apollo Multispecialty Hospitals em Calcutá identificaram um abscesso paratraqueal no pescoço do paciente, que obstruía suas vias aéreas. Esses abscessos podem causar infecções potencialmente fatais, se não forem tratadas a tempo.
O home precisou passar por uma cirurgia e tratamento com medicamentos antifúngicos durante dois meses e se recuperou. Apesar de não trabalhar com o Chondrostereum purpureum, acredita-se que ele possa ter ficado muito exposto a materiais em processo de decomposição.